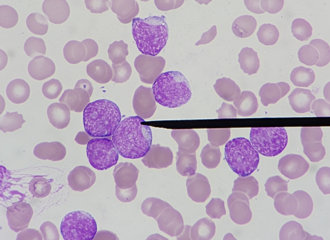
抽菸也會傷骨髓 每天20支抽10年 血癌風險飆2倍

搜尋結果
以下是含有女兒出生的搜尋結果,共169筆
-
2025年剩50天!台中麗寶跨年「首波超狂卡司」公布 全掃金曲獎認可
2025年只剩最後50天,由三立電視主辦的「2026包你發 麗寶跨年演唱會」公布首波強力卡司,包括宇宙人、美秀集團、Marz23,其中Marz23和宇宙人將於年底接力攻蛋,Marz23才率「TRASH」拿下本屆金曲獎最佳樂團,他說:「拚命了這麼多年,算是給了自己一個滿意的成績單,希望新的一年我能夠花更多時間給家人,也讓自己能充分休息、創作。」
-
恭喜!港男星當台灣女婿宣布女兒出生 昔來台考駕照「1次就過」
出道超過20年的46歲香港演員張啟樂2020年定居台灣,2024年以廣播節目《台味超有港》獲頒第59屆廣播金鐘獎生活風格節目獎時,和台灣太太結婚3年的他,今年7月妻子有喜,稍早,他宣布太太昨(4日)平安產下一女,迎來天蠍座千金,他直言第一次感受有生命是因為自己而來這世上,真的會感動痛哭。
-
新生兒大魔王!RSV致命率是流感5倍、住院率更高達16倍
國內流感疫情持續升溫,疾管署預告,整個十月都是高點,但家有新生兒的家長,除了要小心流感、新冠夾擊,更要留意另一個大魔王!感染科權威黃立民今(16)日提醒,新生兒感染RSV後的急診與住院率是流感的16倍、死亡率高出5倍,是造成一歲以下嬰幼兒死亡的主因之一,呼籲完成「左流右新」接種疫苗以外,也應該積極預防RSV
-
台東嗜賭父拋家20年 女兒被迫打黑工 法院判免扶養
台東許男嗜賭成性、積欠債務,20多年前拋家棄子,晚年因罹患惡性腫瘤及多重疾病而臥病衛生福利部台東醫院護理之家,有受扶養之必要,台東地方法院認為許男「無正當理由長期未盡撫養責任,情節重大」,裁定免除女兒的扶養責任,可抗告。
-
MLB》駐美記者曝內幕!大谷的「真美子力量」 當專屬司機超罕見
道奇球星大谷翔平今年球季重拾二刀流,在激烈賽場上繳出亮眼成績,妻子田中真美子協助打理場外事務功不可沒,日媒引述駐美體育記者的說法指,真美子會開車接送大谷上下班,在「大嫂團」之中相當罕見。
-
電影「無名指」揭罕病故事 健保會主委:救命錢一定不會少
電影「無名指」近日上映,描述罕病脊髓性肌肉萎縮症(SMA)病友及家人的生命故事。罕見疾病基金會今晚(26)舉辦電影包場活動,不少罕病家庭共同響應,衛福部健保會主委周麗芳也出席,強調罕病藥費是救命錢,一定不會短少,會持續爭取相關資源。
-
連晨翔幫女兒取小名 劉品言聽了秒翻白眼
連晨翔今(22日)和大元一同出席醫美活動,老婆劉品言在金鐘60以《誰來演戲》入圍「生活風格節目主持人獎」,他表示自己不會陪同,金鐘典禮距離劉品言預產期還有一段時間,不擔心老婆身體狀況,加上有團隊在旁邊照顧,他會好好守在電視前為老婆錄影加油。
-
葉蒨文和林子祥膝下無子 坦言「不喜歡小孩」但孫女1理由例外
葉蒨文和林子祥29年前結婚,最近兩人為了共同演唱會勤跑宣傳,兩人上港媒節目,被問到為何先前不生小孩?葉蒨文大方坦言是因為她「不喜歡小孩」,但繼子林德信的女兒除外,主因是他女兒出生的時間跟葉蒨文母親過世時間相近,加上諸多巧合,讓她覺得這個孫女像是父親或母親來投胎。
-
陸脫口秀演員小佳講的「缺德笑話」 媽祖審完都笑了
大陸這兩年流行「個人脫口秀」節目,脫口秀演員小佳幽默的段子令觀眾印象深刻。據《新周刊》報導,因神經系統先天性疾病,他說話和行動都有障礙,常被他人注視,「審視感」貫穿著小佳的成長過程。他從小害怕理髮,身體總會不由自主地搖晃,高中時他想成為作家,正是想躲到作品背後,逃避人群與目光。
-
恭喜!麋先生貝斯手以諾女兒滿月 活動暴增團員們笑稱真帶財
金曲樂團麋先生MIXER今夏行程滿檔,足跡遍佈十多個城市,團員們表示:「今年暑假我們幾乎沒有真正休息過,但很感謝所有遇見和聽見那些音符詞句的你們,不僅串起了陌生,也放滿了祝福。」而貝斯手以諾近日升格成為新手爸爸,本來人氣就很旺的麋先生,在以諾女兒出生後更是旺上加旺,團員們都開心笑稱,果真是「以諾千金」滿月帶財啊!
-
七夕喜連連 風田宣布結婚 熊仔迎女娃
33歲從日本來台發展、曾是男團spexial成員的風田,29日七夕情人節這天,以手寫信方式分享結婚喜訊。
-
她想參加徵文比賽
她想參加徵文比賽,她想著要不要參加徵文比賽,糾結了好些年。
-
抽菸也會傷骨髓 每天20支抽10年 血癌風險飆2倍
57歲藝人沈玉琳經過多日檢查後,證實罹患俗稱血癌的白血病,醫師黃軒指出,抽菸是造成白血病的風險因子之一,連續10年每天吸超過20支,白血病風險就會上升1.5至2倍,年齡越大、抽菸越久,風險也就越高。
-
恭喜「最美J女郎」平安生了! 閃婚7個月升格當媽
大陸女星李心艾擁有四分之一俄羅斯血統,2013年在周杰倫電影《天台》飾演女主角,被封「最美J女郎」。年初剛宣布結婚的她,昨(5日)證實順利誕下寶貝女兒,網友狂刷一排恭喜。
-
獨家》劉伊心嫁富尪8年成三寶媽 親吐為人母最大改變
「美胸皇后」劉伊心與大24歲的老虎牙子創辦人林志隆結婚八年,先後育有2女1子,螢光幕前總是甜美理性的她,私下面對孩子卻是一位有無限耐心的溫柔媽媽。她在接受訪問時敞開心房,坦言在懷第一胎時,原以為自己會是虎媽型的母親,沒想到在看到孩子的那一刻才發現,自己根本狠不下心。
-
余天爆烏龍死訊 余祥銓發聲曝父現況
個性幽默、親民的余祥銓在父親節前夕,跟老婆柔柔今(1日)出席活動,透露爸爸余天退休後的生活,至於之前網路上的余天烏龍死訊,余祥銓澄清爸爸生活正常,精神狀態也很好,每天最開心就是跟孫女玩,「其實他最想要的父親節禮物,就是希望我再生一胎。」
-
要一個人靜靜就失聯 產檢也不出現!人妻爆炸了怒離
婦人小萱指控丈夫阿國(均化名),2023年7月某日去上班就未回家,她去產檢時也未到醫院,最後一次用LINE回訊息後失聯,公司也不知他的去向。因為阿國的銀行、私人債務很多,擔心出事便通報失蹤人口。後來警方有找到人,但阿國卻說要一個人靜靜,不要回家、也不要與她聯絡。不滿阿國所為,憤而依法訴請離婚。
-
全因女兒一句話! 沈玉琳狂瘦再戒25年菸癮:怕等不到她結婚
沈玉琳昨(29日)驚傳猛爆性肝炎惡化引發腦水腫住院,據悉目前並無上述狀況,雖然有發燒,不過意識相當清醒,讓眾人都鬆了一口氣,近來他不僅鏟肉17公斤,還戒掉25年的菸癮,目的就是希望女兒結婚時,能親手牽著她進禮堂。
-
歐弟新婚爆分居!友揭「打呼聲」成主因 本人14字洩近況
46歲男星歐弟(歐漢聲)2021年與陸籍前妻鄭雲燦結束6年婚姻,去(2024)年又低調與圈外女友登記結婚,且同年9月順利誕下小女兒「波波」,正式升格為3寶爸。怎料結婚不到1年,近日卻傳出歐弟與老婆關係生變,不僅兩人疑似悄悄分居,兩人的婚姻現況更引發鄰居議論。
-
重男輕女差點被送養 成長故事太悲慘!女兒棄養93歲父
婦人小萱指控父親阿國(均化名)重男輕女,曾放話要將她出養,祖母便帶她四處躲藏以免遭到出養,約她國小二年級時,父母離異後母親再婚,父親則長住宮廟,對她不聞問未盡扶養義務,之後祖母帶她寄住姑姑家,父親就算偶爾回來,卻對她拳腳相向。不滿父親所為,憤而訴請免除扶養義務。